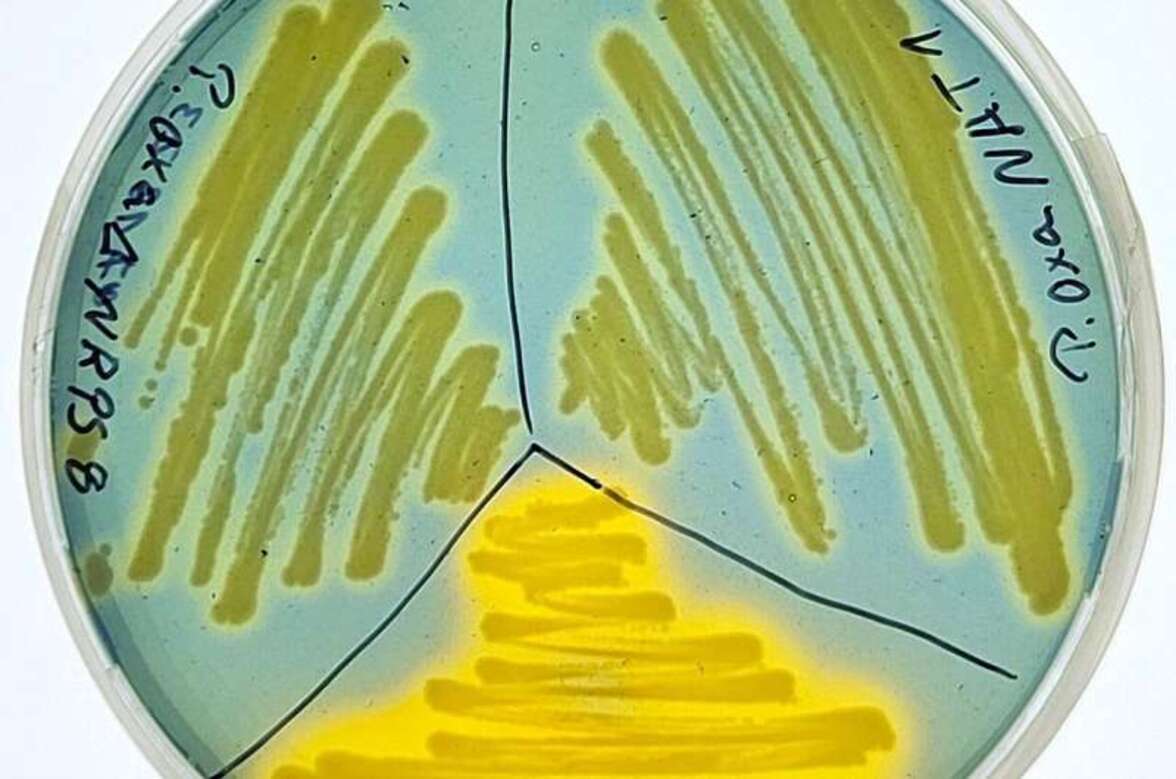
Бактерии Pandoraea выделяют уникальные молекулы, нарушающие баланс микробиома легких

Резистентные к антибиотикам бактерии рода Pandoraea, часто попадающие в окружающую среду, являются одной из новых причин оппортунистических респираторных инфекций, особенно у пациентов с муковисцидозом.
Однако их специфические метаболиты, включая нишевые факторы и факторы вирулентности, оставались неизвестными. Междисциплинарная исследовательская группа, возглавляемая Институтом Лейбница (Германия), обнаружила новую группу биоактивных природных соединений выделяемых бактериями Pandoraea: пандорабактины. Они позволяют бактериям извлекать жизненно важное железо из других микроорганизмов и, таким образом, влиять на микробный баланс в легких человека. Результаты исследования опубликованы в журнале Angewandte Chemie International Edition.
Бактерии рода Pandoraea на сегодняшний день практически не изучены. Их название напоминает о ящике Пандоры из греческой мифологии, который является символом неконтролируемой опасности. "Мы изучали бактерии Pandoraea на предмет устойчивости к антибиотикам", - рассказала первый автор публикации Елена Герцог. "Однако, выяснилось, что как и многие другие явления в природе, эти болезнетворные бактерии обладают не только отрицательными свойствами. Бактерии Pandoraea также производят натуральные продукты с антибактериальным эффектом".
Несмотря на высокий риск для здоровья, который представляют Pandoraea, их молекулярные свойства до сих пор были малоизвестны. "Мы знали только, что эти бактерии встречаются в природе и что они могут быть патогенными, потому что они были обнаружены в микробиоме легких пациентов с муковисцидозом или сепсисом", - говорит Герцог. Как и для большинства живых организмов, железо также необходимо бактериям. "Железо играет центральную роль, например, в ферментах и дыхательной цепи живых организмов", - объясняет Герцог.
В среде с низким содержанием железа, такой как организм человека, условия для достаточного усвоения этого элемента далеки от идеальных. Поэтому многие микроорганизмы вырабатывают так называемые сидерофоры - небольшие молекулы, которые связывают железо из окружающей среды и переносят его в клетку. "Однако у бактерий Pandoraea не было известных факторов вирулентности или ниши, которые могли бы помочь им выжить", - говорит Герцог. Поэтому исследовательская группа хотела выяснить, как штаммы Pandoraea могут выживать в такой конкурентной среде.
Используя биоинформатический анализ, ученые идентифицировали ранее неизвестный кластер генов под названием pan. Он кодирует нерибосомальную пептидсинтетазу — типичный фермент для производства сидерофоров. "Мы начали с анализа кластеров генов и специально искали гены, которые могли бы отвечать за производство сидерофоров", - рассказывает Герцог. Благодаря целенаправленной инактивации генов, а также методам, основанным на культивировании, и современным аналитическим методам, включая масс-спектрометрию, ЯМР-спектроскопию, химическую деструкцию и дериватизацию, исследователям удалось выделить два новых натуральных продукта пандорабактин А и В и выяснить их химическую структуру: .
Оба они способны образовывать комплексы с железом и могут играть важную роль в выживании штаммов Pandoraea в сложных условиях. "Эти молекулы помогают бактериям усваивать железо, когда его не хватает в окружающей среде", - объясняет Герцог. Биологические анализы и масс-спектрометрия показали, что пандорабактины обладают антибактериальной активностью в отношении различных легочных патогенов (Pseudomonas, Mycobacterium и Stenotrophomonas) за счет снижения содержания железа в организме бактерий-конкурентов.
В совокупности, эти результаты дают первое представление о нишевых факторах Pandoraea и указывают на то, что пандорабактины формируют микробиоту пораженных легких, конкурируя за железо. "Однако пока еще слишком рано делать выводы о применении этих результатов в медицине", - подчеркивает Герцог. Тем не менее, открытие предоставляет важную информацию о стратегиях выживания бактерий рода Pandoraea в организме человека.